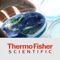
Thermo Fisher Scientific is the world leader in serving science and is uniquely positioned to help customers accelerate innovation and drive productivity

You are using an outdated browser. Please
upgrade your browser to improve your experience.

Thermo Fisher Scientific is the world leader in serving science and is uniquely positioned to help customers accelerate innovation and drive productivity
Thermo Fisher Market Reach
by Kaon Interactive, Inc.



What is it about?
Thermo Fisher Scientific is the world leader in serving science and is uniquely positioned to help customers accelerate innovation and drive productivity.

App Screenshots





App Store Description
Thermo Fisher Scientific is the world leader in serving science and is uniquely positioned to help customers accelerate innovation and drive productivity.
The Thermo Fisher Scientific Market Reach app demonstrates the depth and breadth of its capabilities for the scientific community.
Features:
• Global reach and innovation
• Corporate overview and value
• Featured applications outlining holistic (enterprise-wide) offerings to key scientific sectors
• Market solutions
• Expansive product listings
Disclaimer:
AppAdvice does not own this application and only provides images and links contained in the iTunes Search API, to help our users find the best apps to download. If you are the developer of this app and would like your information removed, please send a request to takedown@appadvice.com and your information will be removed.
AppAdvice does not own this application and only provides images and links contained in the iTunes Search API, to help our users find the best apps to download. If you are the developer of this app and would like your information removed, please send a request to takedown@appadvice.com and your information will be removed.